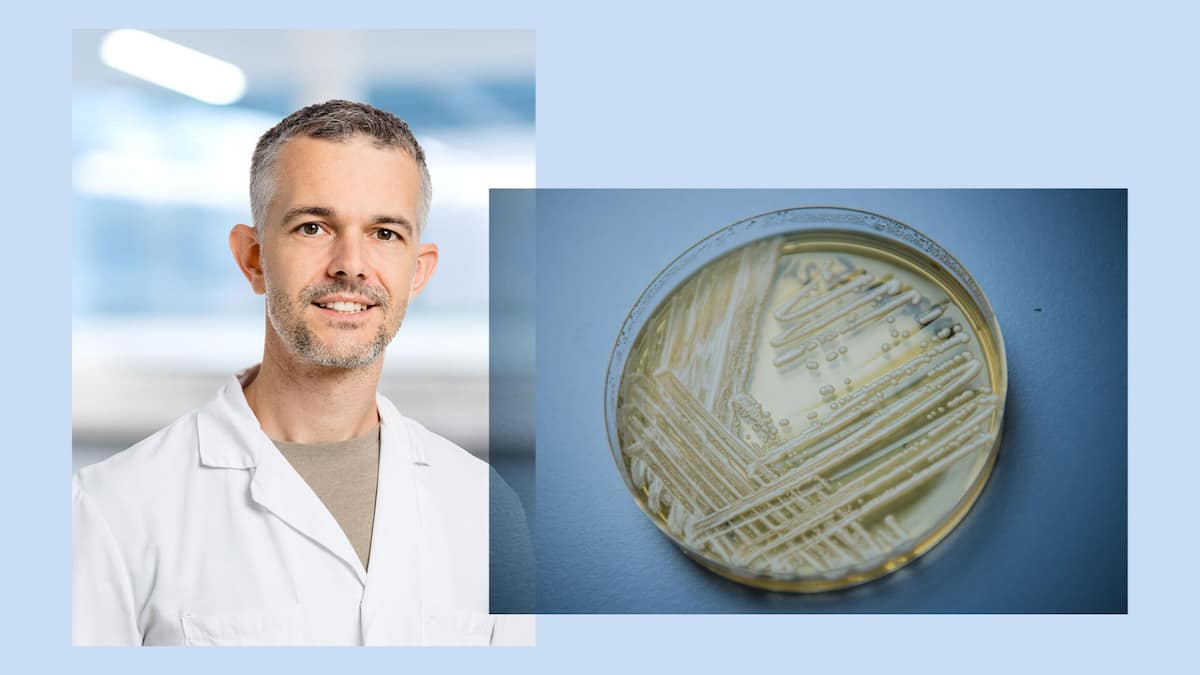

Beobachter: Philipp Jent, wie gefährlich ist der resistente Pilz Candidozyma auris, der sich in europäischen Krankenhäusern ausbreitet und auch schon in der Schweiz gemeldet wurde?
Philipp Jent: Candidozyma auris ist besonders problematisch, weil er häufig gegen gängige Antipilzmittel resistent ist und aussergewöhnlich lange auf Oberflächen überlebt. Dadurch kommt es in vielen Ländern zu Ausbrüchen in Spitälern und Pflegeheimen, und der Erreger konnte sich weltweit rasch verbreiten.



